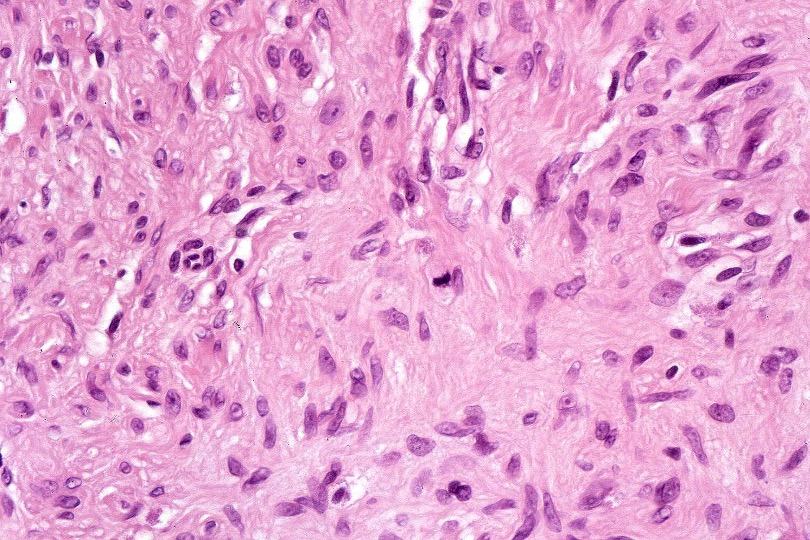
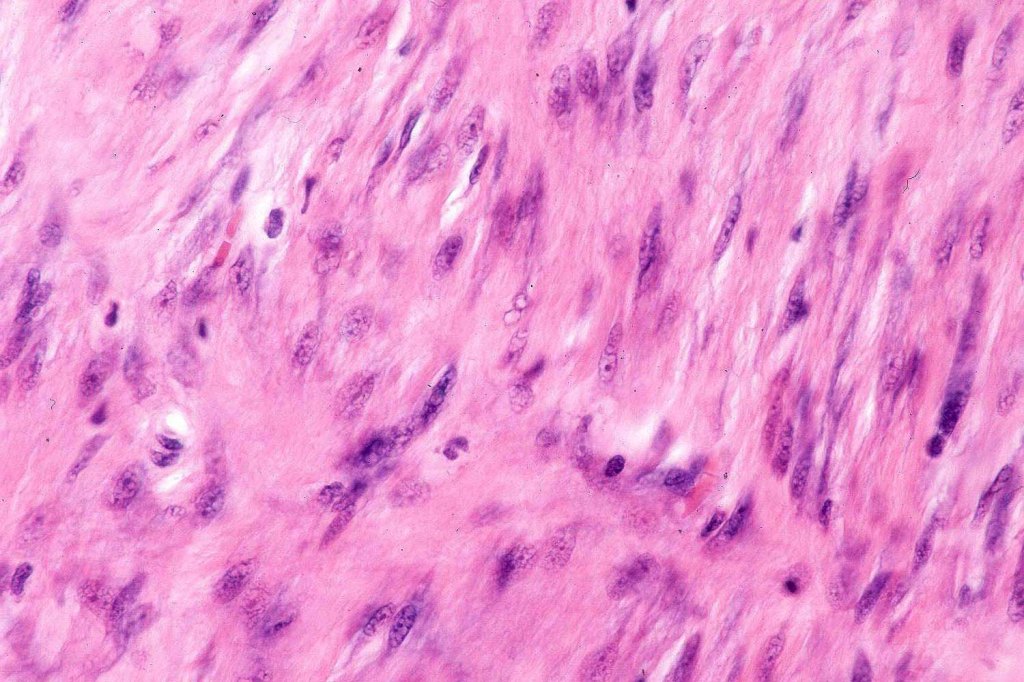
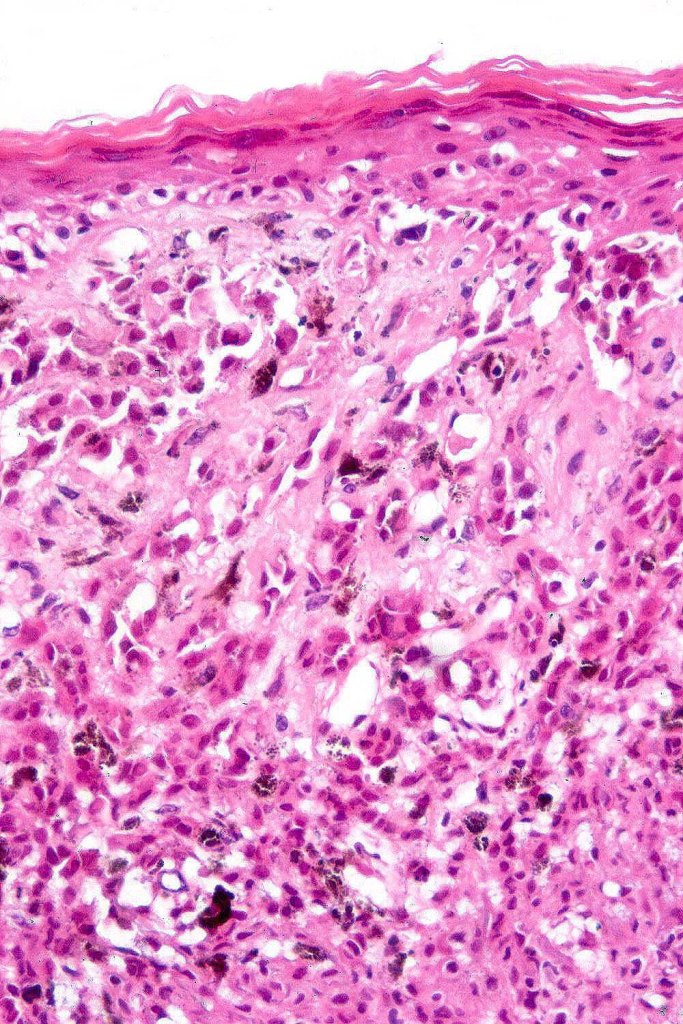
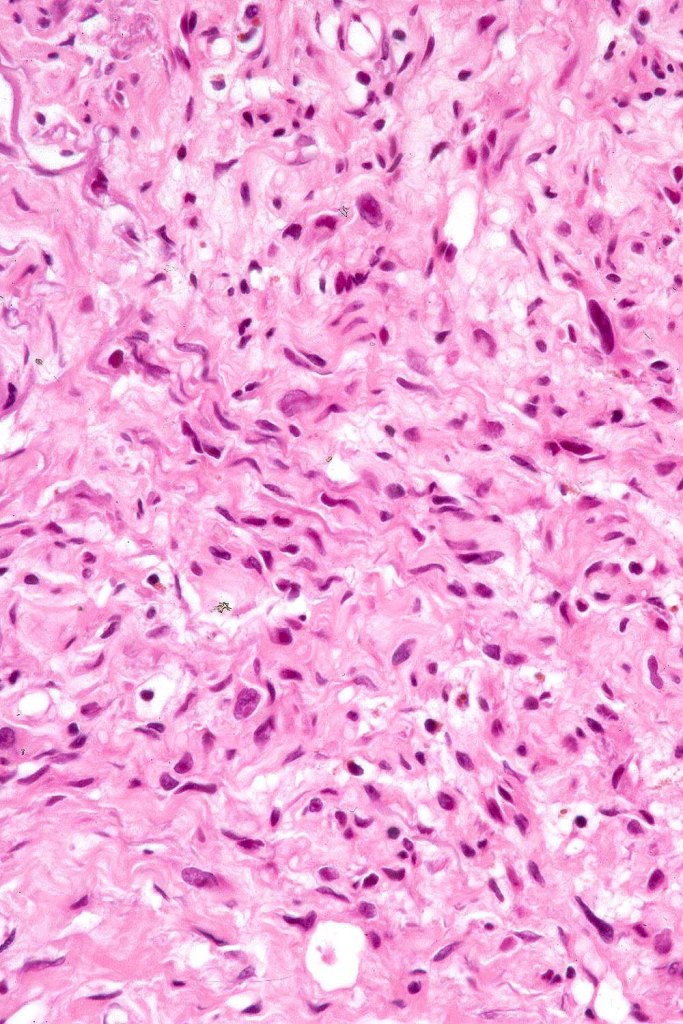
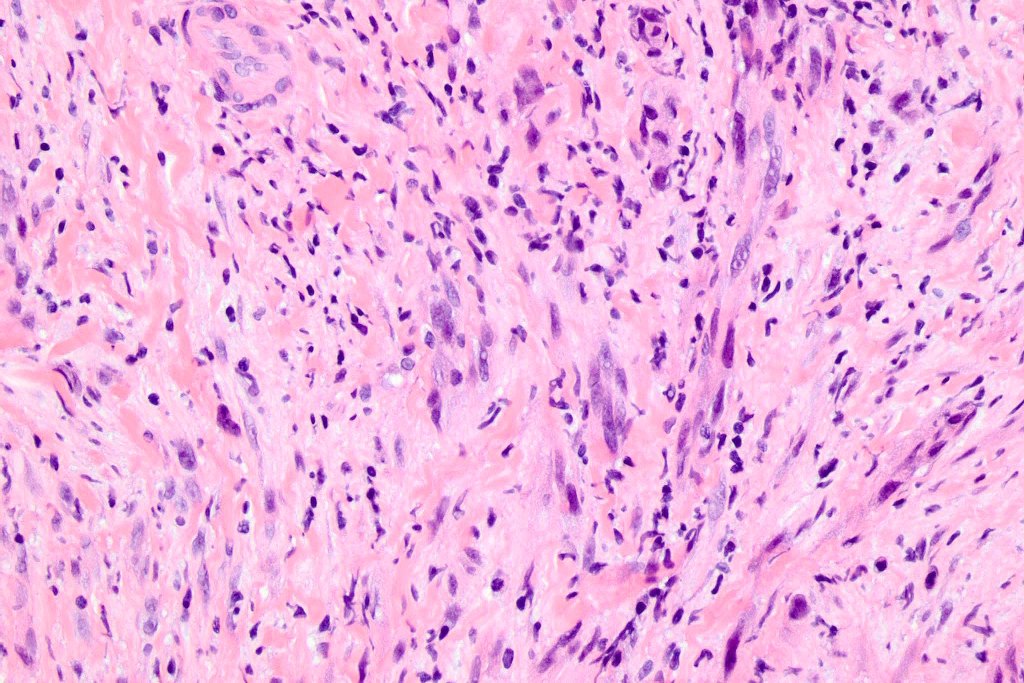

A rare variant of melanoma which may exists as a pure subtype or represent part of a conventional melanoma where a more typical spindled morphology is present (this second subtype behaves no differently from any other melanoma).
Clinical features
•Rare sub-type (<4%)
•High CSD
•Head, neck & upper trunk++,
•Scalp alopecia
•+/- MIS
•Around 50% amelanotic nodule/plaque
•M-70%
•Older age groups (median 60)
•Lymph nodes rarely involved (pure variants)
. 5-year survival around 79%
. Pure desmoplastic variant frequently recurs & can be deeply invasive
Histological features
•+/- Lentigo maligna (some examples are devoid of a junctional component)
•Paucicellular spindle cell infiltrate with “myxoid” fine to a dense collagenous stroma
•Hyperchromatic nuclei
•Variable pleomorphism
•Lymphoid aggregates*
•Neurotropism
•Neural transformation
•Mixed desmoplastic & spindle cell variant (10%)

Immunohistochemistry & molecular data
•S100, SOX10, NFGR +ve
•HMB45, Mart1 –ve
•CD57 to highlight nerves
•NF1 mutations (55%)
•Amplification of receptor kinase genes (EGFR,MET,ERBB2)
•Inactivation of CBL
•CDKN2A mutation (47%)
•TP53 mutation (48%)
. Absence of BRAFV600E
Differential diagnosis
Pure forms require a high index of suspicion and frequently IHC is required if a junctional component is not evident. Desmoplastic melanoma can be mistaken for a scar (never report on a scar if the clinical history doesn’t detail what the original lesion was!!) Other tumors with which it can be confused include desmoplastic spindle cell squamous carcinoma, neurofibroma, dermatofibroma, nodular fasciitis, fibromatosis, spindle cell atypical fibroxanthoma, sarcoma particularly neurofibrosarcoma (especially if only a shave biopsy is submitted).

Leave a comment